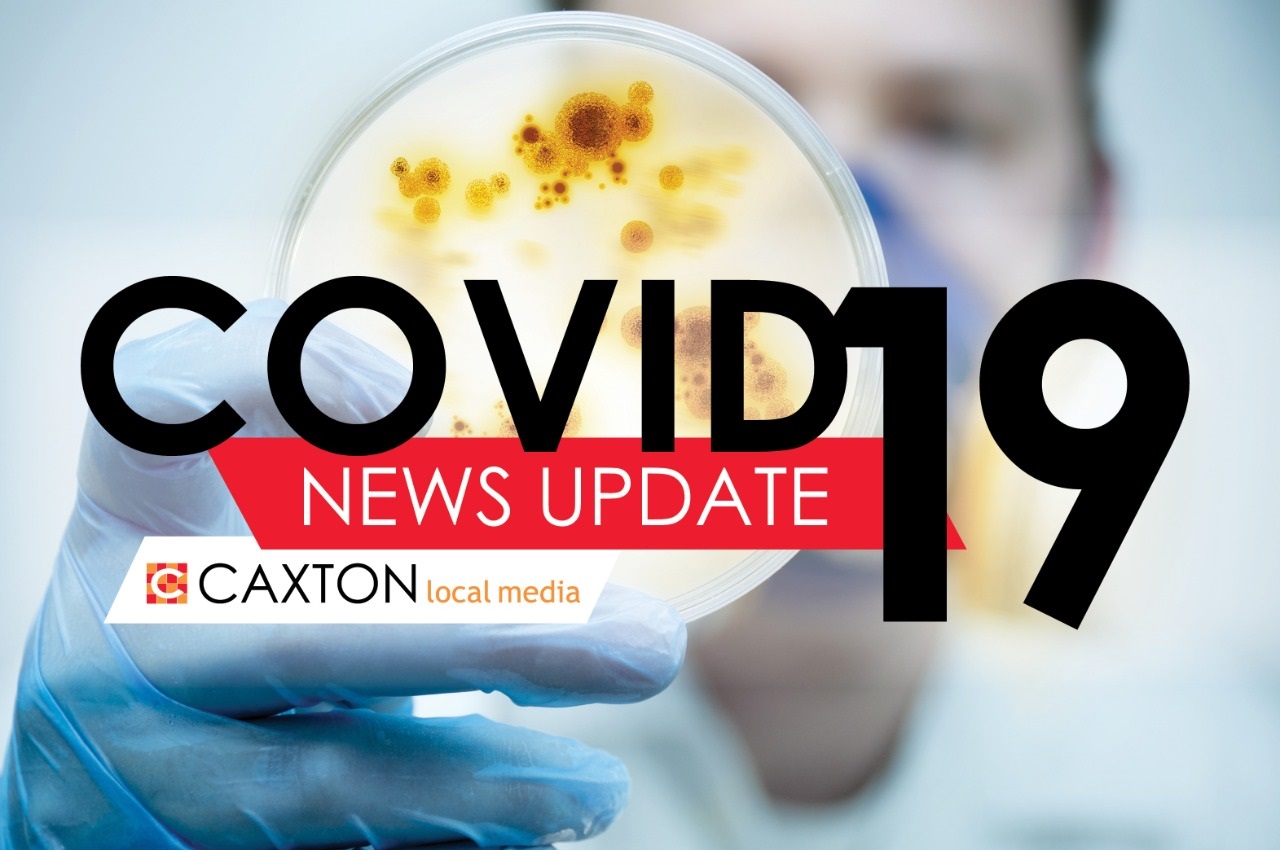

Covid-19: Baby clothes, towels and other essentials can be sold during lockdown, maybe even cheaper
The Department of Trade, Industry and Competition says there is provision for the sell of baby products to a certain age during the lockdown.
There has been some confusion as to whether or not baby clothes are an essential item and if parents can buy baby products during the 21-day lockdown.
Regarding regulations published in the Government Notice R398 of 25 March 2020, the Department of Trade, Industry and Competition said in a statement, “Regulations published on 25 March included, under paragraph 6(a), the following inclusion as an essential good: (iv) Products for the care of babies and toddlers.”
It said the provision includes baby clothes, blankets, towels and other essential accessories for newborns, infants and toddlers up to 36 months old.
All stores that are currently permitted to remain open during the lockdown, including supermarkets, can sell the mention above products. The department added, “We have been in contact with the CEOs of the large retailers, who have undertaken to sell these products at prices which simply cover their basic costs of production and distribution for the period of the lockdown.”
Hospitals and clinics can also procure these products as necessary to provide for the infants in their care, the department concluded.
* Notice: Coronavirus reporting at Caxton Local Media aims to combat fake news
Dear reader,
As your local news provider, we have the duty of keeping you factually informed on Covid-19 developments. As you may have noticed, mis- and disinformation (also known as “fake news”) is circulating online. Caxton Local Media is determined to filter through the masses of information doing the rounds and to separate truth from untruth in order to keep you adequately informed. Local newsrooms follow a strict pre-publication fact-checking protocol. A national task team has been established to assist in bringing you credible news reports on Covid-19.
Readers with any comments or queries may contact National Group Editor Irma Green (irma@caxton.co.za) or Legal Adviser Helene Eloff (helene@caxton.co.za).


